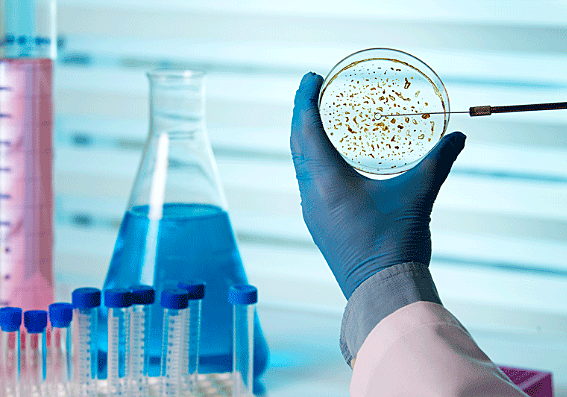
Medicina

-
Desarrollaron la primera escritura registrada, números y calendarios.
-
Desarrollaron grandes obras de irrigación, drenajes y canales importantes para la agricultura y la vida en la ciudad. Desarrollaron los números arábigos, sistema decimal
-
Inventaron la brújula, la pólvora, el papel y la imprenta. Estas herramientas permitieron el intercambio de ideas de entre civilizaciones, lo que fomentó la generación de nuevas ideas.
-
Considerada la cuna de nuestra civilización debido a que es la que poseemos la mayor información histórica. Desarrollaron la zoología, botánica, mineralogía, arquitectura e ingeniería.
-
Hasta donde se sabe, el primero en buscar explicación de los fenómenos naturales. Por ejemplo, terremotos y relámpagos.
-
Avances en matemáticas, propuso que la Tierra es esférica y creó una escuela esotérica.
-
Desarrollos de la filosofía, astronomía, ciencias naturales, fisiología y metabolismo. Sirvió de puente para la propagación de ideas de la India hacia otros lados.
-
Filosofía y razonamiento deductivo.
-
Junto con su maestro Platón, filosofía y razonamiento deductivo
-
Gracias a los jeroglíficos se sabe que desarrollaron la Alquimia, Astronomía, Matemáticas, Geometría y Medicina.
-
Modelo heliocéntrico del sistema solar.
-
Calculó la circunferencia de la Tierra.
-
Los puentes, drenajes, calefacción, acueductos y baños.
-
Creó la Enciclopedia Naturalis Historia.
-
Desarrollo de la Geografía, Óptica, Música, Astrología y Astronomía.
-
Desarrollo de la Medicina: Anatomía, Fisiología, Patología, Farmacología y Neurología.
-
Después de la caída del Imperio Bizantino, también conocido como la Edad Oscura.
-
Se extendieron desde España hasta la India. Concentraron mucho del conocimiento de Grecia, Persia, India y China.
-
Desde los siglos XIII - XIV, alcanzaron a dominar casi toda Asia y parte del Este de Europa.
-
Inicia con la caída de Constantinopla entre el siglo XV-XVIII.
-
Astronomía: Copérnico, Kepler, Galileo y otros, aceptaron el modelo heliocentrista.
Medicina: Andreas Vesalius desarrolló la Anatomía moderna haciendo disecciones de cadáveres.
William Harvi.- primera descripción del sistema circulatorio.
Grandes avances en la Física y Matemáticas con Hugeans, Newton, Fermald, Boyler, entre otros.
Se desarrolló el cálculo y los logaritmos
Pascal desarrolló la primera calculadora mecánica.
Newton propuso la Ley de Gravitación Universal y las Leyes de la Mecánica. -
Se basa en el análisis y lógica.
-
Se empezaron a describir los elementos que actualmente vemos en la tabla periódica, y a proponer leyes de la materia.
-
Se descubrió los microorganismos, se desarrollaron la higiene, vacunas y antibióticos.
-
Se basa en la observación y Experimentación
-
Comienza con la revolución francesa y continua hasta la actualidad.
-
Empezaron a clasificarse distintas especies, dando lugar al desarrollo de la Taxonomía por Lineo
-
Se desarrolló la Teoría de la Evolución por Charles Darwin. Explica cómo todos los seres vivos fueron formados por selección natural a través de largos periodos de tiempo.
-
Dimitri Mendeleiev propone la tabla periódica
-
El dominio de la electricidad ayudó al desarrollo de telégrafos. Abrió paso también al desarrollo de la electricidad. Desarrollo de las primeras computadoras.
-
Empiezan a estudiar los fenómenos de manera independiente de su sustrato, lo que nos permite estudiar diferentes sistemas. También permite la comunicación de distintas disciplinas ya que todas hablan del mismo lenguaje.
-
Empezamos a diseñar y controlar seres vivos, principalmente para la producción de comida y medicinas.
A list shows items. A timeline shows sequence.
Use Timetoast to make dates, milestones, and turning points easier to understand in a clear visual format. Timetoast is a timeline maker for work, school, research, and stories.